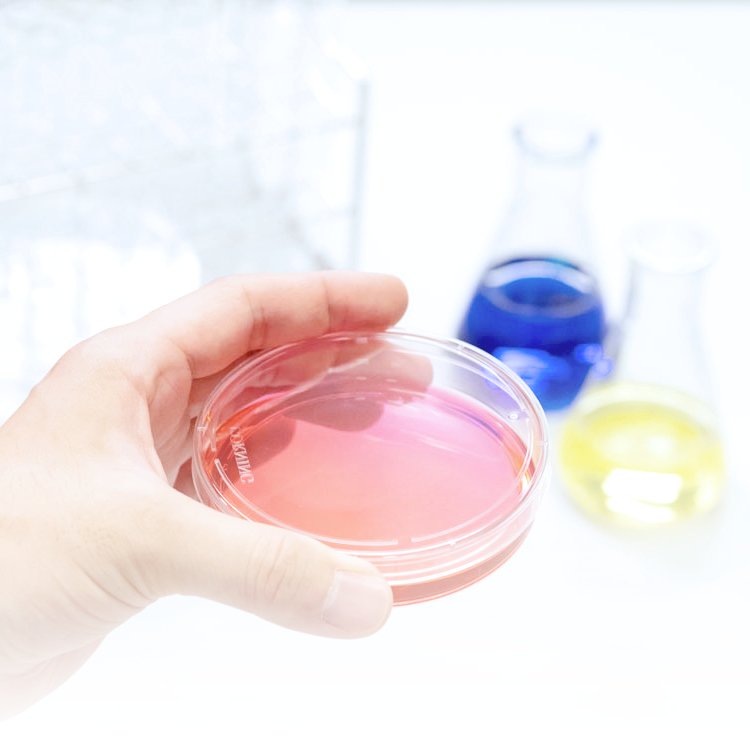
富士フイルム和光純薬株式会社

マイストア
変更
お店で受け取る
(送料無料)
配送する
納期目安:
2026.03.05 13:49頃のお届け予定です。
決済方法が、クレジット、代金引換の場合に限ります。その他の決済方法の場合はこちらをご確認ください。
※土・日・祝日の注文の場合や在庫状況によって、商品のお届けにお時間をいただく場合がございます。
ファンデーション Wako WAKOクロック/WAKO: グッズ - 宝塚クリエイティブアーツ公式の詳細情報
WAKOクロック/WAKO: グッズ - 宝塚クリエイティブアーツ公式。WAKOクロック/WAKO: グッズ - 宝塚クリエイティブアーツ公式。。


クレ・ド・ポーボーテ タンプードルエクラ|| オークル10
写真の商品になります。【新品未使用】CHRISTINA ROSEDEMER カバークリーム。オークル10 レフィル×1個専用ケース×1個新品未開封 計2点プチプチに包みダンボールに入れて発送致します。新品未開封イザノックス パワーフィットクッションEXファンデーション 4個セット。



クレ・ド・ポーボーテ タンプードルエクラ|| オークル10
写真の商品になります。【新品未使用】CHRISTINA ROSEDEMER カバークリーム。オークル10 レフィル×1個専用ケース×1個新品未開封 計2点プチプチに包みダンボールに入れて発送致します。新品未開封イザノックス パワーフィットクッションEXファンデーション 4個セット。
ベストセラーランキングです
近くの売り場の商品
カスタマーレビュー
オススメ度 4.8点
現在、3488件のレビューが投稿されています。